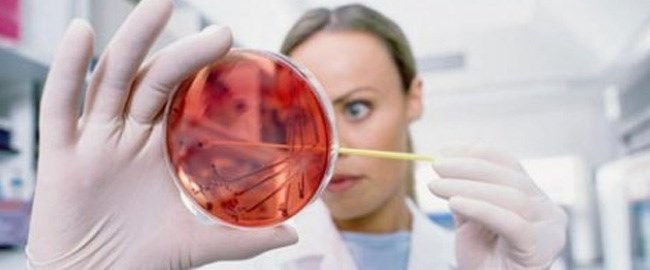

Hepatitin tedavi edilebilir bir hastalık olduğunu söyleyen Gastroenteroloji-Hepatoloji Uzmanı Prof. Dr. Levent Erdem, “Hepatitsiz Dünya” sloganı ile toplumda farkındalık oluşturulmasının hedeflendiğini dile getirerek, kronik B ve C enfeksiyonuna bağlı viral hepatitlerde son derece etkili ve kolay alınan ilaçlarla iyileşmenin mümkün olduğunu belirtti.
Hepatit C’de virüsü yok eden tedavinin başarı oranının %95’in üzerinde olduğunu ifade eden Demiroğlu Bilim Üniversitesi, Gastroenteroloji-Hepatoloji Bölüm Başkanı Prof. Dr. Levent Erdem, “Bu nedenle herkesi hepatit testlerini yaptırmaya çağırıyoruz. Basit bir kan tahlili ile tanı koyarak, karaciğer yetmezliği ve kansere yol açabilen hepatit B ve C’yi ilaçla tedavi edebilir, kontrol altına alır veya kür sağlayabiliriz” dedi.
Hepatit B ve C’de erken tedavinin önemine vurgu yapan ve “Siroz veya karaciğer kanseri gelişmiş hastalarda tedaviye rağmen istenen iyileşme tam olarak sağlanamayabilir ve bazı riskler ortadan kaldırılamaz. Bu hastaların bazıları ancak karaciğer nakli ile hayatta kalabilir. Bu nedenle siroz oluşmadan gerekli önlemleri almak, erken tanı ile tedaviyi sağlamak yaşamsal önem taşır” uyarısında bulunan Doktor Levent Erdem, hepatit ile ilgili güncel verileri şöyle aktardı:
"Dünya Sağlık Örgütü’nün 2018 verilerine göre;
- Dünyada 325 milyon viral hepatit B ve C’li hasta var.
- Her yıl yaklaşık 3 milyon yeni enfeksiyonlu birey söz konusu.
- Hepatit B ve C’li kişilerin %80’i tanı konmamış durumda.
- Tanı konulanların ancak %10-20’si tedavi alıyor.
- Yılda 1.4 milyon insan hepatit B ve C’ye bağlı siroz ve kanserden kaybediliyor."
Viral hepatitler içinde yer alan Hepatit B ve Hepatit C’nin yol açtığı kronik enfeksiyonun, karaciğer sirozu ve karaciğer kanserinin %70-80’inin sebebi olduğunu dile getiren Prof. Erdem, hepatitin yol açtığı Sağlık sorunları ve tedavi yolları hakkında şu bilgileri verdi:
“İlk infeksiyon hastaların sadece %20’sinde aşikar sarılık yapar, %80 hastada sessiz, sarılık olmaksızın geçirilir. Sıklıkla tanı konulamayan sessiz ilk infeksiyon sonrası oluşan kronik viral infeksiyon 10-50 yıl arası gibi uzun bir belirtisiz dönemden sonra siroz ve kansere sebep olur. Klinik belirtiler ancak hastalık çok ilerlediği zaman ortaya çıkar.
SİROZA BAĞLI KARACİĞER YETERSİZLİĞİ VE KANSER EN SIK ÖLÜM SEBEBİ!
Binlerce insanın hayatta kalması ancak karaciğer nakli ile sağlanır. Türkiyede karaciğer nakli konusunda çok deneyimli ve başarılı merkezler vardır fakat bizim hedefimiz hastaların karaciğer nakli aşamasına gelmeden saptanması ve gerekirse tedavi edilmesidir. İlaçla tedavide sağlanan ilerlemeler ve karaciğer nakline rağmen dünyada her yıl yaklaşık 1.4 milyon kişi bu kronik hepatit B ve C sebebiyle yaşamını kaybediyor. Hepatitleri küresel bir sağlık sorunu haline getiren bu tablo kader değildir. Gerek etkili ve emniyetli hepatit B aşısı uygulaması, gerekse kronik B hepatiti ve kronik C hepatiti için sahip olduğumuz etkili ilaçlarla Dünya Sağlık Örgütü’nün belirlediği 2030 yılı hedeflerine ulaşmak mümkündür.
HEPATİTLE ETKİN MÜCADELE İÇİN HANGİ ENGELLER AŞILMALI?
En önemli ve endişe verici gerçek kronik B ve C hepatitl hastalarının %80’inin tanı konulmamış, hastalığından habersiz normal yaşamını sürdürüyor olmasıdır. Dünyada 250 milyon kronik B hepatitli ve 75 milyon civarında da kronik C hepatitli insan var. Türkiye’de ise 2.5 milyon kronik B ve 500 bin civarında kronik C infeksiyonlu hastanın olması söz konusudur. Yani milyonlarca kişi hem karaciğer sirozu ve kanseri gibi ciddi hastalıklara maruz kalma riski altındadır hem de en başta aile üyeleri olmak üzere diğer kişiler için bulaş kaynağıdır. Öncelikle hastalığından habersiz milyonlarca hepatit B ve C’li hastaya tanı konulması gerekiyor. Herkes en az bir kez kendisi ve ailesi için bu hepatit B ve C tarama testlerini yaptırmalıdır. Bu ihmal edilmemesi gereken bir konudur.
“VİRAL HEPATİTLİ HASTA KALMASIN”
Her türlü çaba gösterilerek tanı konulan ve hastalığın erken döneminde iken tedavi edilen hasta sayısını bugünkünün en az 3-4 katına çıkarmamız gerekmektedir. Hedef rakam her yıl kronik hepatit B’li ve kronik hepatit C’li en az 15 bin, tercihen 30 bin hastanın tedavi edilmesidir.
“HERKES TEST YAPTIRSIN, HEPATİT HASTALARI TEDAVİ OLSUN”
Viral hepatitli ancak hastalığından habersiz yüzbinlerce insane ulaşmak, onların tedavisi ile ciddi hastalık ve ölümlere engel olmak, aynı zamanda diğer insanlara bulaşı önleyerek toplumda viral hepatit infeksiyonunu kontrol altına almak gerekir.”
Prof. Dr. Levent Erdem
Prof. Dr. Levent Erdem
Toplumsal bilinç kazanmanın önemi ile viral hepatitlerin, dünyadaki en önemli ve aynı zamanda önlenebilir sağlık sorunları arasında yer aldığına vurgu yapan Prof. Dr. Levent Erdem, “Viral hepatitlere karşı koruyucu aşı, etkili ilaçlar, ulaşılabilir tedavi olanakları, etkin sosyal güvenlik sistemimiz ve konuyu çok iyi bilen uzman doktorlarımız var. Eksik olan ise bu konudaki toplumsal farkındalığın az olması. Bunun için de öncelikle riskli gruplar başta olmak üzere herkesin hepatit B ve C tarama testlerinin yapılması, virüs taşıdığı belirlenen kişilerin tedavi programına alınması, ilaç tedavilerine başlanması, ailenin diğer fertlerinin de taranarak virüslere karşı önlem alınması gerekiyor” açıklamasını yaptı.
AŞILANMAKTAN KORKMAYIN!
Aşılama ile aktif korunmanın, ülkemizde ve dünyada hepatit B infeksiyonuna karşı en etkin ve emniyetli mücadele şekli olduğunu yineleyen “Asla ihmal edilmemeli, uygulama tavizsiz ve kesintisiz olarak sürdürülmelidir” vurgusu yapan Prof. Dr. Levent Erdem, özellikle ülkemizdeki duruma değinerek, “Yenidoğanlar, bebekler, ilköğretim çağındakilerin tamamı ve erişkin yaştaki risk gruplarında yer alanlar aşılanmalıdır. Ailelerin, çocukların aşılanmasına yönelik yanlış bilgileri itibar etmemesi çok önemlidir. Hepatit B aşısının yan etkileri ve bazı nadir görülen hastalıkların sebebi olabileceğine ilişkin bilimsel dayanağı olmayan görüş ve yayınlara rağmen, yapılan geniş araştırmalar ve uzun süreli izlemelerde bu hastalıklar açısından herhangi bir risk olmadığı gösterilmiştir. Hepatit B aşı programı sayesinde Tayvan, İtalya ve Türkiye başta olmak üzere birçok ülkede hepatit B sıklığında %50 ve üzerinde azalma sağlanmıştır. Buna paralel olarak karaciğer sirozu ve kanserinde de belirgin azalma olması beklenmektedir” şeklinde konuştu.
NTV